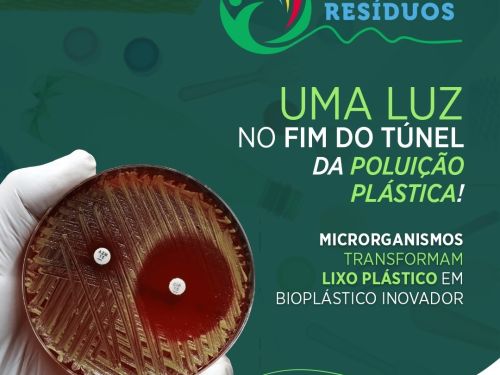
Feira Mineira de Resíduos 2025

Feira Mineira de Resíduos 2025
Descrição
Nos dias 27 e 28 de agosto, o Centerminas Expo, na região nordeste de Belo Horizonte, será palco da 4ª edição da Feira Mineira de Resíduos, um dos principais encontros do setor de limpeza urbana e gestão de resíduos em Minas Gerais. Realizado pelo Sindicato das Empresas de Limpeza Urbana no Estado de Minas Gerais (SINDILURB-MG), o evento deste ano traz como tema “O Futuro dos Resíduos: soluções que redefinem o amanhã”.
A programação reunirá mais de 100 empresas, expositores qualificados e especialistas renomados para apresentar inovações, tecnologias e serviços voltados à gestão eficiente de resíduos, reciclagem e economia circular. Também será espaço para debates estratégicos sobre políticas públicas, desafios ambientais e oportunidades de negócios no setor.
A 4ª edição da Feira Mineira de Resíduos será estruturada em painéis que contarão com a participação de especialistas renomados do setor. No primeiro dia, 27 de agosto, ocorrerão dois painéis. O Painel 1, terá como tema “Estratégia Mineira para o Encerramento dos Lixões e a Gestão Adequada de Resíduos Sólidos Urbanos em Minas Gerais”, já o Painel 2 será “O Retorno que Gera Valor: Logística Reversa em Foco”.
No segundo dia de evento, a programação seguirá com três painéis: o Painel 3 – “O Futuro do Tratamento de Resíduos no Brasil”, o Painel 4 – “Gestão Inteligente de Resíduos: O Futuro Começa Aqui” e o Painel 5 – “O Amanhã Não Vai Esperar! Liderança, Disrupção e os Riscos de Não Mudar Enquanto Ainda Há Tempo”.
Aberta ao público, a Feira Mineira de Resíduos 2025 é destinada a empresários, gestores públicos, profissionais técnicos, acadêmicos e demais interessados no tema. A entrada gratuita é mediante retirada de ingressos no site do Sympla.
Localização
Avenida Pastor Anselmo Silvestre, 1495 - 4º Andar - União